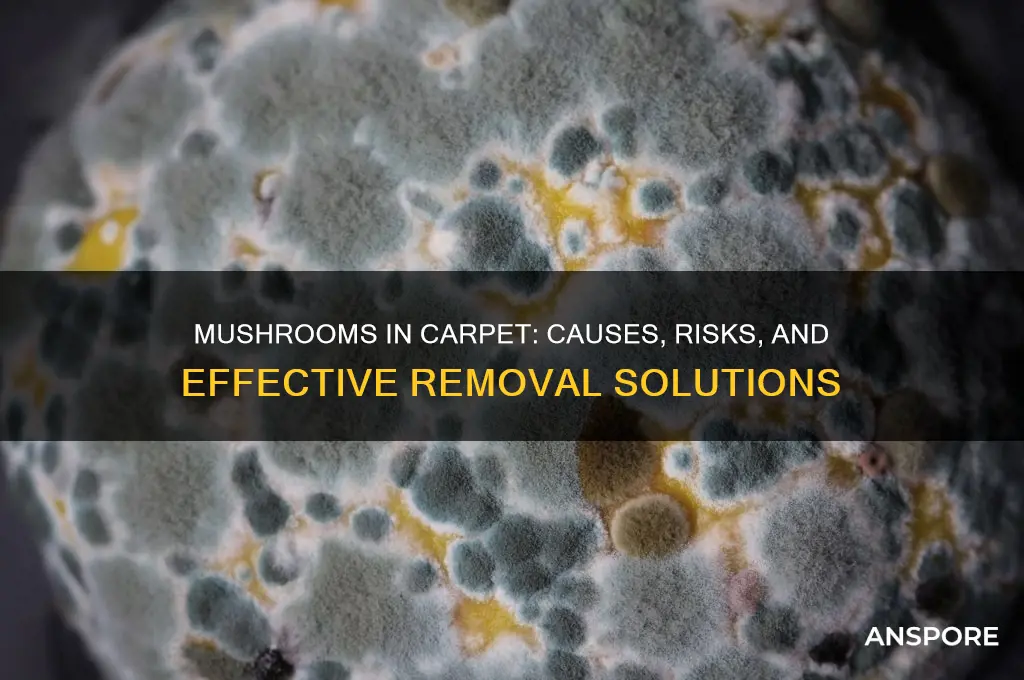
why are mushrooms growing in my carpet

Discovering mushrooms growing in your carpet can be both surprising and concerning, as it typically indicates underlying moisture or mold issues within your home. Mushrooms thrive in damp, dark environments, and their presence suggests that excess water or humidity has penetrated the carpet, subflooring, or padding, creating ideal conditions for fungal growth. Common causes include leaks from pipes, poor ventilation, flooding, or even high humidity levels. Beyond being unsightly, these fungi can pose health risks, such as allergies or respiratory problems, and may signal structural damage. Addressing the issue promptly by identifying the moisture source, drying the affected area, and potentially replacing damaged materials is crucial to prevent further growth and ensure a healthy living environment.
| Characteristics | Values |
|---|---|
| Moisture | High humidity or water damage in carpet or subfloor. Common causes include leaks, spills, or poor ventilation. |
| Organic Matter | Presence of organic material (e.g., wood, dust, pet dander, or food particles) in the carpet or padding, which mushrooms use as food. |
| Darkness | Mushrooms thrive in dark environments, such as under furniture or in closets, where light exposure is minimal. |
| Temperature | Optimal growth occurs in temperatures between 55°F and 85°F (13°C and 29°C), typical of indoor environments. |
| Poor Airflow | Stagnant air or lack of ventilation traps moisture, creating ideal conditions for mushroom growth. |
| Carpet Age | Older carpets may retain more moisture and organic debris, increasing the likelihood of mushroom growth. |
| Subfloor Issues | Rotten or damp subfloors (e.g., from plumbing leaks) can provide a hidden environment for mushrooms to develop. |
| Mold Presence | Existing mold in the carpet or subfloor often indicates similar conditions (moisture, organic matter) that support mushroom growth. |
| Pet Accidents | Urine or feces in the carpet can introduce moisture and nutrients, fostering mushroom growth. |
| Outdoor Contamination | Soil or plant material tracked indoors can introduce mushroom spores into the carpet. |
Explore related products
What You'll Learn
- Excess moisture in carpet creates ideal mushroom growth conditions
- Poor ventilation traps humidity, fostering fungal development
- Organic matter beneath carpet serves as mushroom food source
- Leaks or spills provide water for mushroom spores to thrive
- Lack of sunlight in carpeted areas encourages mushroom growth

Excess moisture in carpet creates ideal mushroom growth conditions
Mushrooms growing in your carpet are a clear sign of excess moisture, which creates the perfect environment for fungal growth. Mushrooms thrive in damp, dark, and organic-rich conditions, and your carpet, when wet, provides all three. Excess moisture can come from various sources, such as leaks, spills, high humidity, or inadequate ventilation. When moisture becomes trapped in the carpet fibers and padding, it creates a breeding ground for mold and mushrooms. The organic materials in the carpet, such as dust, pet dander, and food particles, serve as a food source for the fungi, allowing them to grow and spread rapidly.
The presence of mushrooms in your carpet indicates that the moisture issue has been ongoing, as fungal growth requires time to develop. Mold and mildew often precede mushroom growth, as they are more resilient and can establish themselves in less favorable conditions. However, once the environment becomes more hospitable, mushrooms will begin to sprout. The carpet's porous nature allows moisture to penetrate deep into the fibers and padding, making it difficult to dry completely. This trapped moisture creates a humid microclimate, ideal for mushroom spores to germinate and grow. If left unaddressed, the fungal growth can spread, causing further damage to your carpet and potentially affecting your indoor air quality.
To prevent mushrooms from growing in your carpet, it's crucial to address the source of excess moisture. Start by identifying and fixing any leaks, spills, or areas of high humidity. Use dehumidifiers or fans to improve air circulation and reduce moisture levels. If the carpet has been affected by a significant water event, such as a flood, it may be necessary to remove and replace the carpet and padding to prevent further fungal growth. Regularly cleaning and vacuuming your carpet can also help eliminate organic materials that serve as food sources for fungi. Additionally, consider using a moisture meter to monitor humidity levels in your home, ensuring they remain below 60% to discourage mold and mushroom growth.
In cases where mushrooms have already appeared, it's essential to take immediate action to remove them and address the underlying moisture issue. Carefully remove the mushrooms, wearing gloves and a mask to avoid inhaling spores. Clean the affected area with a solution of water and mild detergent, followed by a disinfectant to kill any remaining fungal spores. If the infestation is severe or the moisture problem persists, consult a professional mold remediation specialist. They can assess the situation, identify the source of moisture, and provide effective solutions to prevent future fungal growth. Remember, addressing excess moisture is key to eliminating the ideal conditions for mushroom growth in your carpet.
Maintaining a dry and well-ventilated environment is crucial in preventing mushrooms from growing in your carpet. Regularly inspect your home for signs of moisture, such as musty odors, water stains, or damp spots. Pay particular attention to areas prone to moisture accumulation, like basements, bathrooms, and kitchens. By staying proactive and addressing moisture issues promptly, you can create an environment that is inhospitable to fungal growth. Keep in mind that mushrooms in your carpet are not just a cosmetic issue but can also pose health risks, as they release spores that may cause allergies or respiratory problems. Taking a comprehensive approach to moisture control will not only protect your carpet but also contribute to a healthier indoor living space.
Cultivating Psychedelic Mushrooms: A Comprehensive Guide to Growing Techniques
You may want to see also

Poor ventilation traps humidity, fostering fungal development
Mushrooms growing in your carpet are a clear sign of excess moisture and poor environmental conditions within your home. One of the primary culprits behind this issue is poor ventilation, which traps humidity and creates an ideal breeding ground for fungal growth. When air circulation is inadequate, moisture becomes stagnant, especially in areas like basements, bathrooms, or rooms with carpets. This trapped humidity permeates the carpet fibers, padding, and even the subfloor, providing the damp environment mushrooms need to thrive. Without proper airflow to dry out these areas, the moisture lingers, fostering fungal spores that eventually develop into visible mushrooms.
To address this problem, it’s essential to improve ventilation in the affected areas. Start by opening windows and doors to allow fresh air to circulate, reducing humidity levels naturally. If the room lacks windows or has limited airflow, consider using fans or dehumidifiers to actively remove moisture from the air. Dehumidifiers are particularly effective in spaces prone to dampness, as they extract excess water vapor, making the environment less hospitable for fungal growth. Regularly running these devices can significantly decrease the humidity that mushrooms rely on to grow.
Another critical step is to identify and fix the source of moisture. Poor ventilation often exacerbates existing water issues, such as leaks, condensation, or high humidity from daily activities like showering or cooking. Inspect the area for hidden leaks in pipes, walls, or ceilings, and repair them promptly. Additionally, ensure that rooms with high moisture production, like kitchens and bathrooms, are properly vented to the outside. Installing exhaust fans or vents can help expel humid air before it settles into carpets or other porous materials.
Incorporating routine maintenance can also prevent the recurrence of mushrooms in your carpet. Regularly clean and vacuum the area to remove any visible mold or mildew, which can release spores that contribute to mushroom growth. If the carpet is already heavily infested, it may need to be professionally cleaned or replaced, especially if the padding underneath is damp and moldy. Replacing old or damaged padding with moisture-resistant materials can further discourage fungal development.
Finally, monitor humidity levels in your home to stay proactive. Ideal indoor humidity should be kept below 50%, as higher levels encourage mold and mushroom growth. Use a hygrometer to track humidity in problem areas and take corrective actions when levels rise. By combining improved ventilation, moisture control, and regular upkeep, you can eliminate the conditions that allow mushrooms to grow in your carpet and maintain a healthier living environment.
When Do Magic Mushrooms Grow in England: Seasonal Guide
You may want to see also

Organic matter beneath carpet serves as mushroom food source
Mushrooms growing in your carpet are a clear sign that there is organic matter beneath the surface providing them with a food source. Carpets, especially those in high-moisture areas or older homes, can trap and conceal organic debris over time. Common culprits include spilled food, pet accidents, dead insects, or even remnants of natural materials like wood or plant fibers. When these materials decompose, they create a nutrient-rich environment that fungi, including mushrooms, thrive on. This organic matter essentially acts as a buffet for mushroom mycelium, the root-like structure that grows beneath the surface.
The presence of organic matter beneath the carpet is often exacerbated by poor ventilation and high humidity, which accelerate decomposition and create ideal conditions for fungal growth. If your carpet has been exposed to water damage, leaks, or excessive moisture, it’s more likely to harbor organic debris. Over time, this debris breaks down into simpler compounds that mushrooms can easily absorb for nourishment. Even small amounts of organic material can sustain mushroom growth, especially if the environment remains damp and undisturbed.
To address this issue, it’s crucial to identify and remove the organic matter beneath the carpet. Start by inspecting the affected area for signs of spills, stains, or hidden debris. If the carpet has been flooded or exposed to moisture, there may be mold, mildew, or rotting underpadding contributing to the problem. In some cases, pulling up the carpet and cleaning or replacing the underpadding may be necessary to eliminate the food source for the mushrooms. Thoroughly vacuuming and cleaning the area can also help remove surface-level organic particles.
Preventing future mushroom growth requires eliminating both the organic matter and the moisture that supports its decomposition. Ensure the area is well-ventilated and address any leaks or humidity issues. If the carpet is in a high-risk area, such as a basement or bathroom, consider using moisture-resistant materials or regularly inspecting for hidden organic debris. By removing the food source and maintaining a dry environment, you can effectively stop mushrooms from returning.
In summary, organic matter beneath your carpet serves as a primary food source for mushrooms, enabling them to grow and spread. Identifying and removing this debris, along with controlling moisture levels, is essential to resolving the issue. Regular maintenance and vigilance can prevent organic material from accumulating and creating a hospitable environment for fungi. If the problem persists, consulting a professional to assess the extent of the organic matter and underlying conditions may be necessary.
Why Mushrooms Suddenly Appear in Your Lawn: Causes Explained
You may want to see also
Explore related products
$25.95 $27.99

Leaks or spills provide water for mushroom spores to thrive
Mushrooms growing in your carpet are a clear sign of excess moisture, and leaks or spills are often the culprits. When water seeps into your carpet, whether from a leaky pipe, a spilled drink, or even condensation, it creates a damp environment that mushroom spores find irresistible. These spores are everywhere, floating in the air and settling on surfaces, but they remain dormant until they encounter the right conditions to grow. Water is a critical factor, as it activates the spores and provides the hydration they need to sprout and develop into mushrooms.
Leaks, even small ones, can go unnoticed for long periods, especially if they occur under the carpet or in hidden areas like walls or ceilings. Over time, the accumulated moisture creates a breeding ground for mold and mushrooms. Spills, on the other hand, might seem harmless if cleaned up quickly, but if any moisture remains deep within the carpet fibers or padding, it can still support fungal growth. Both scenarios highlight the importance of addressing water issues promptly to prevent mushroom infestations.
Carpet padding, in particular, is highly absorbent and retains moisture longer than the carpet itself. When leaks or spills penetrate this layer, it becomes a perfect habitat for mushrooms. The padding stays damp, providing a consistent water source for spores to thrive. Even if the surface of the carpet appears dry, the underlying padding can still harbor enough moisture to sustain fungal growth. This is why mushrooms often appear in areas where water damage might not be immediately visible.
To combat this issue, it’s essential to identify and fix the source of the water intrusion. Inspect your home for leaks, paying close attention to plumbing fixtures, roofs, and windows. For spills, ensure thorough cleaning by using a wet vacuum or professional cleaning service to remove all moisture from the carpet and padding. If the carpet remains damp despite your efforts, consider removing and replacing the affected areas to eliminate the risk of recurring mushroom growth.
Preventing future leaks and spills is equally important. Use waterproof barriers under carpets in moisture-prone areas, and address any plumbing or structural issues promptly. Regularly inspect your home for signs of water damage, such as discoloration or a musty odor, which can indicate hidden moisture problems. By keeping your environment dry, you deprive mushroom spores of the water they need to grow, effectively stopping the problem at its source.
Are Lawn Mushrooms Safe? Identifying Poisonous Grass-Growing Fungi
You may want to see also

Lack of sunlight in carpeted areas encourages mushroom growth
Mushrooms growing in your carpet can be a surprising and unwelcome discovery, and one of the primary reasons behind this phenomenon is the lack of sunlight in carpeted areas. Sunlight plays a crucial role in inhibiting the growth of fungi, including mushrooms, by creating an environment that is less conducive to their development. Carpeted areas, especially those in basements, closets, or rooms with minimal natural light, often become breeding grounds for mushrooms due to the absence of this natural deterrent. Sunlight not only dries out moisture but also contains ultraviolet (UV) rays that can kill fungal spores, preventing them from germinating and spreading.
When carpeted areas are deprived of sunlight, they create a dark, damp environment that mushrooms thrive in. Fungi, including mushrooms, require darkness to grow, as light can disrupt their life cycle. Carpet fibers can trap moisture from spills, humidity, or even cleaning activities, providing the necessary dampness for spores to take root. Without sunlight to dry out these areas, the moisture lingers, creating the perfect conditions for mushroom growth. This is why mushrooms often appear in corners, under furniture, or in areas where light rarely penetrates.
Another factor tied to the lack of sunlight is poor air circulation. Sunlit areas tend to have better airflow, which helps in keeping surfaces dry and less hospitable to fungi. In contrast, carpeted areas without sunlight often suffer from stagnant air, allowing moisture to accumulate and fungal spores to settle and grow undisturbed. This combination of darkness, moisture, and still air transforms your carpet into an ideal habitat for mushrooms.
To address this issue, increasing sunlight exposure in carpeted areas is essential. Moving furniture to allow more natural light to reach the carpet, using mirrors or reflective surfaces to bounce light into darker corners, or even installing additional lighting can help. Additionally, ensuring proper ventilation and using dehumidifiers can reduce moisture levels, making the environment less favorable for mushroom growth. Regularly vacuuming and cleaning the carpet can also remove fungal spores before they have a chance to develop.
In summary, the lack of sunlight in carpeted areas is a significant contributor to mushroom growth, as it creates a dark, damp, and stagnant environment that fungi thrive in. By taking steps to introduce more light, improve air circulation, and control moisture, you can effectively prevent mushrooms from taking over your carpet. Addressing these underlying conditions not only eliminates existing mushrooms but also discourages future growth, keeping your home healthier and fungus-free.
Exploring Vermont's Forests: Do Psychedelic Mushrooms Thrive in the Green Mountain State?
You may want to see also
Frequently asked questions
Mushrooms grow in carpets due to excessive moisture, poor ventilation, and the presence of organic material (like dust, dirt, or food particles) that serves as a food source for fungal growth.
Remove the mushrooms carefully, clean the area with a vinegar or bleach solution to kill spores, and address the underlying moisture issue, such as fixing leaks or improving ventilation.
Some mushrooms can be toxic or cause allergic reactions, and their presence indicates mold or mildew, which can harm indoor air quality and health. It’s best to remove them promptly.
Yes, mushrooms and the mold they indicate can stain, weaken, or deteriorate carpet fibers over time, especially if the moisture problem persists.
Maintain low humidity levels, fix water leaks, ensure proper ventilation, and regularly clean your carpet to remove organic debris that fungi feed on.
























